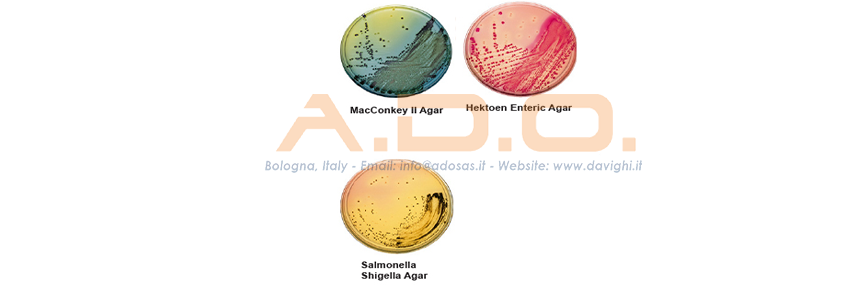
Placas listas para usar

BECTON DICKINSON
Productos, Soluciones y Servicios para la Microbiología Clínica y la Industria.

Política de seguridad (editar con módulo de tranquilidad del cliente)
Política de entrega (editar con módulo de tranquilidad para el cliente)
Política de devoluciones (editar con módulo de tranquilidad para el cliente)
El objetivo de Becton Dickinson es apoyar la práctica del Laboratorio de Microbiología en cada fase del proceso productivo, desde la recolección de la muestra hasta la gestión útil y activa de la información, poniendo a disposición la experiencia de las personas, la historia y los productos de una empresa líder en la investigación y desarrollo de la diagnóstica microbiológica. Sin olvidar nunca el fin último: La centralidad del Laboratorio de microbiología para una terapia del paciente oportuna, eficaz y eficiente.
A.D.O. MEDICAL es el distribuidor oficial de los productos de laboratorio de la empresa Becton Dickinson.
NB:
PARA LA BÚSQUEDA CON CÓDIGO Y/O DESCRIPCIÓN:

BECTON DICKINSON
Productos, Soluciones y Servicios para la Microbiología Clínica y la Industria.